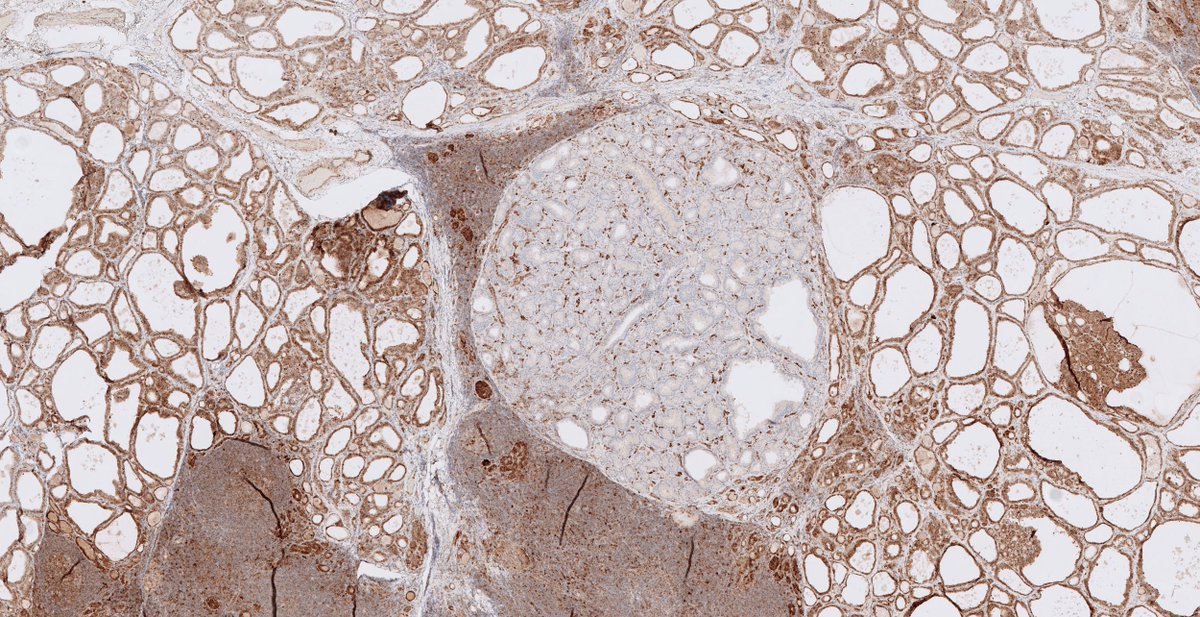
C. Christofer Juhlin tweet media

ทวีตที่ปักหมุด

Looking for that #ENTPath review in the literature that you wish was there but simply isn't? Learn & drop that knowledge! Scrape together & mold the info into a beautifully sculpted work of English prose & send it into @HeadNeckPathol! #PathArt springer.com/journal/12105

English